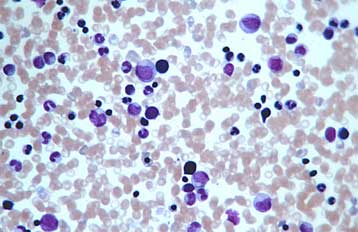

Ο πρώτος τεχνητός ανθρώπινος μυελός των οστών που μπορεί να παράγει συνεχώς ερυθρά και λευκά αιμοσφαίρια δημιουργήθηκε σε αμερικανικό εργαστήριο.
Οι ερευνητές του Πανεπιστημίου του Μίσιγκαν ελπίζουν ότι το σύστημα που ανέπτυξαν στο δοκιμαστικό σωλήνα θα χρησιμοποιηθεί στο μέλλον για δοκιμές φαρμάκων, για τη μελέτη των λευκών αιμοσφαιρίων, καθώς και για την παραγωγή αίματος για μεταγγίσεις.
Δεν προορίζεται πάντως για μεταμοσχεύσεις.
«Πρόκειται για τον πρώτο τεχνητό μυελό των οστών» δήλωσε ο καθηγητής Νίκολας Κότοφ, κύριος συγγραφέας της μελέτης που δημοσιεύεται στην επιθεώρηση Biomaterials. «Διαθέτει δύο από τις βασικές λειτουργίες του μυελού των οστών: Μπορεί να παράγει βλαστικά κύτταρα του αίματος καθώς και Β κύτταρα, τα οποία είναι βασικά κύτταρα του ανοσοποιητικού συστήματος σημαντικά για την καταπολέμηση πολλών ασθενειών» εξήγησε.
Ο μυελός των οστών είναι ένας περίπλοκος ιστός τον οποίο οι ερευνητές χρειάστηκε να αντιγράψουν σε μικροσκοπικό επίπεδο. Βασικό τους πρόβλημα ήταν το πώς θα μπορούσαν να μιμηθούν την τρισδιάστατη διάταξη των κυττάρων μέσα στα κοιλώματα των ανθρώπινων οστών.
Προκειμένου να αναδημιουργήσει αυτή τη δομή μέσα στο δοκιμαστικό σωλήνα, η ομάδα του Δρ Κότοφ χρησιμοποίησε ένα τζεκ από πολυμερές υλικό μέσα στο οποίο τοποθέτησε με ακρίβεια μικροσκοπικά σφαιρίδια.
Όταν τα σφαιρίδια αυτά διαλύθηκαν με χημικά, άφησαν πίσω τους ένα γεωμετρικά τέλειο δίκτυο από μικρές οπές, οι οποίες αποτέλεσαν τη «σκαλωσιά» πάνω στην οποία αναπτύχθηκαν τα κύτταρα.
Στην τελική φάση της μελέτης οι ερευνητές έδειξαν ότι το σύστημα αντιδρά στον ιό της γρίπης όπως και ο κανονικός μυελός των οστών, ενώ όταν μεταμοσχευτεί σε ποντίκια με βλάβες του ανοσοποιητικού συστήματος παράγει λευκά αιμοσφαίρια και διεγείρει τοπικά τον σχηματισμό νέων αγγείων.